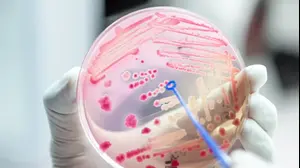
צלחת פטרי עם חיידקים

וואלה
פוש מסומן:
חזרה
פושים בזמן אמת:
mako
התיעוד שמוכיח: בצלב האדום היו מודעים לשקר של חמאס
N12
ניצן שפירא @ צ'אט כתבים
צה"ל פועל במנהרות באזור ח'אן יונס שעד כה נמנע מלפעול בהן - מחשש לפגיעה בחיי החטופים
ישראל היום
אוי גוועלד
הסדרה האהובה עשתה טעות מביכה - ויהודים ברחבי העולם זועמים
וואלה
סוף לדיונים מרחוק? המחדל שיחזיר את העצורים לבתי המשפט | אורי סלע
ישראל היום
לקראת "עצרת המיליון"
מי ישתתף בהפגנות הענק בירושלים, מי ייעדר - ומפת החסימות המלאה | עושים סדר
N12
חשיפה: השקר של הצלב האדום נחשף מול המצלמות - וגם: אילנה דיין עם האמירה של פלדשטיין לחוקרי השב"כ
וואלה
אירופה בלחץ: למרות האיום הרוסי, הצעד המדאיג שנקטה ארה"ב
N12
איחוד פלגים שלא נראה כבר עשור: כך תיראה "עצרת המיליון" של החרדים
ישראל היום
זה לא רק אצלכם
תקלה עולמית במיקרוסופט: אלפי משתמשים נותקו משירותי הענן
mako
כזה עוד לא ראינו: הסכום העצום שבעל צ'יינג' נאשם שהלבין
ישראל היום
5 פצועים בתאונה סמוך ליישוב קציר: בן 61 במצב אנוש, פעוט במצב קשה
mako
תאונת דרכים סמוך לקציר: בן 61 במצב אנוש, בן 3 במצב קשה ושלושה פצועים נוספים במצב קל
וואלה
5 פצועים בתאונת דרכים קשה סמוך לחריש, גבר במצב אנוש ופעוט במצב קשה
mako
אושר סלים על הפדיחה על המסלול בשבוע האופנה: "לא מתרגשת מעירום"
ישראל היום